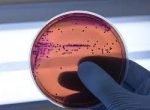

Cidade e região
-

21ª Semana Nacional dos Museus teve início de forma presencial na noite desta terça-feira (16)
17/05/2023O início da exposição ocorreu na Igreja Matriz com o terço cantado
-

Obras de canalização da avenida do Catiguá seguem sendo realizadas pelo terceiro dia
17/05/2023Em relação ao trânsito, está bloqueada a passagem somente no perímetro da obra
-

Saiba os prós e contras do consumo do chocolate
16/05/2023Em primeiro lugar, opte pelo produto com maior teor de cacau possível
-

Projeto de lei que cria colar de girassol para pessoas com doenças ocultas foi sancionado pelo prefeito municipal
16/05/2023A lei tem finalidade de evitar que pessoas portadoras dessas doenças passem por situações constrangedoras
-

5ª Edição do Prêmio de Produtividade de Café ACARPA está com as inscrições abertas
16/05/2023Para participar dos é necessário uma preencher a ficha de cadastro
-

Ministério da Saúde libera vacinação contra gripe para população
16/05/2023 -

10 ambulâncias são entregues para reforçar o atendimento de saúde em Patrocínio
15/05/2023As ambulâncias em questão são do tipo A, que garantem maior qualidade no transporte e segurança para os passageiros
-

Hospital do Câncer de Patrocínio expandirá atendimento para mais 27 municípios da região
15/05/2023 -

Se uma mosca ou outro inseto pousa na comida, ainda é seguro comer?
15/05/2023A verdade indigesta é que as moscas carregam diversos patógenos
-
Superbactérias: uma ameaça pior que a covid-19
15/05/2023Um estudo revelou um aumento de 700% nos casos de superbactérias na infância
-

Ações estão sendo realizadas em prol da construção da Igreja de Frei Galvão
15/05/2023Geraldo Magela convidou a todos para participar da Feijoada da Comunidade de São Frei Galvão
-

Secretaria Municipal de Desenvolvimento Social dará início a sua tradicional Campanha do Agasalho
15/05/2023A mesma tem o objetivo de atender as pessoas que sentem frio e não tem condição de estar adquirindo seu agasalho
-

Por meio dos vereadores, 15 mães foram homenageadas pela Câmara Municipal de Patrocínio
15/05/2023Muitas das homenageadas ostentavam além da honraria de ser mãe, também a de ser avó, e até bisavó
-

Patrocínio se prepara para a 21ª Semana Nacional dos Museus com foco na sustentabilidade e bem-estar
11/05/2023 -

Abertas as inscrições para o processo seletivo de membros do Conselho Tutelar de Patrocínio
11/05/2023 -

Câmara Municipal de Patrocínio aprova projetos do prefeito em reunião ordinária
10/05/2023 -

Projeto de revitalização do Parque da Matinha está em andamento
10/05/2023 -

Sindicato dos Trabalhadores Rurais de Patrocínio realiza Show de Prêmios em comemoração ao Dia das Mães
08/05/2023 -

Vereador propõe projeto de modernização do Calçadão da Praça Santa Luzia
08/05/2023 -

Nesta semana acontece a posse das 622 pessoas aprovadas no Concurso Público de Patrocínio
08/05/2023O prefeito Deiró Marra também falou sobre as rodovias CMG-462 e BR-365.